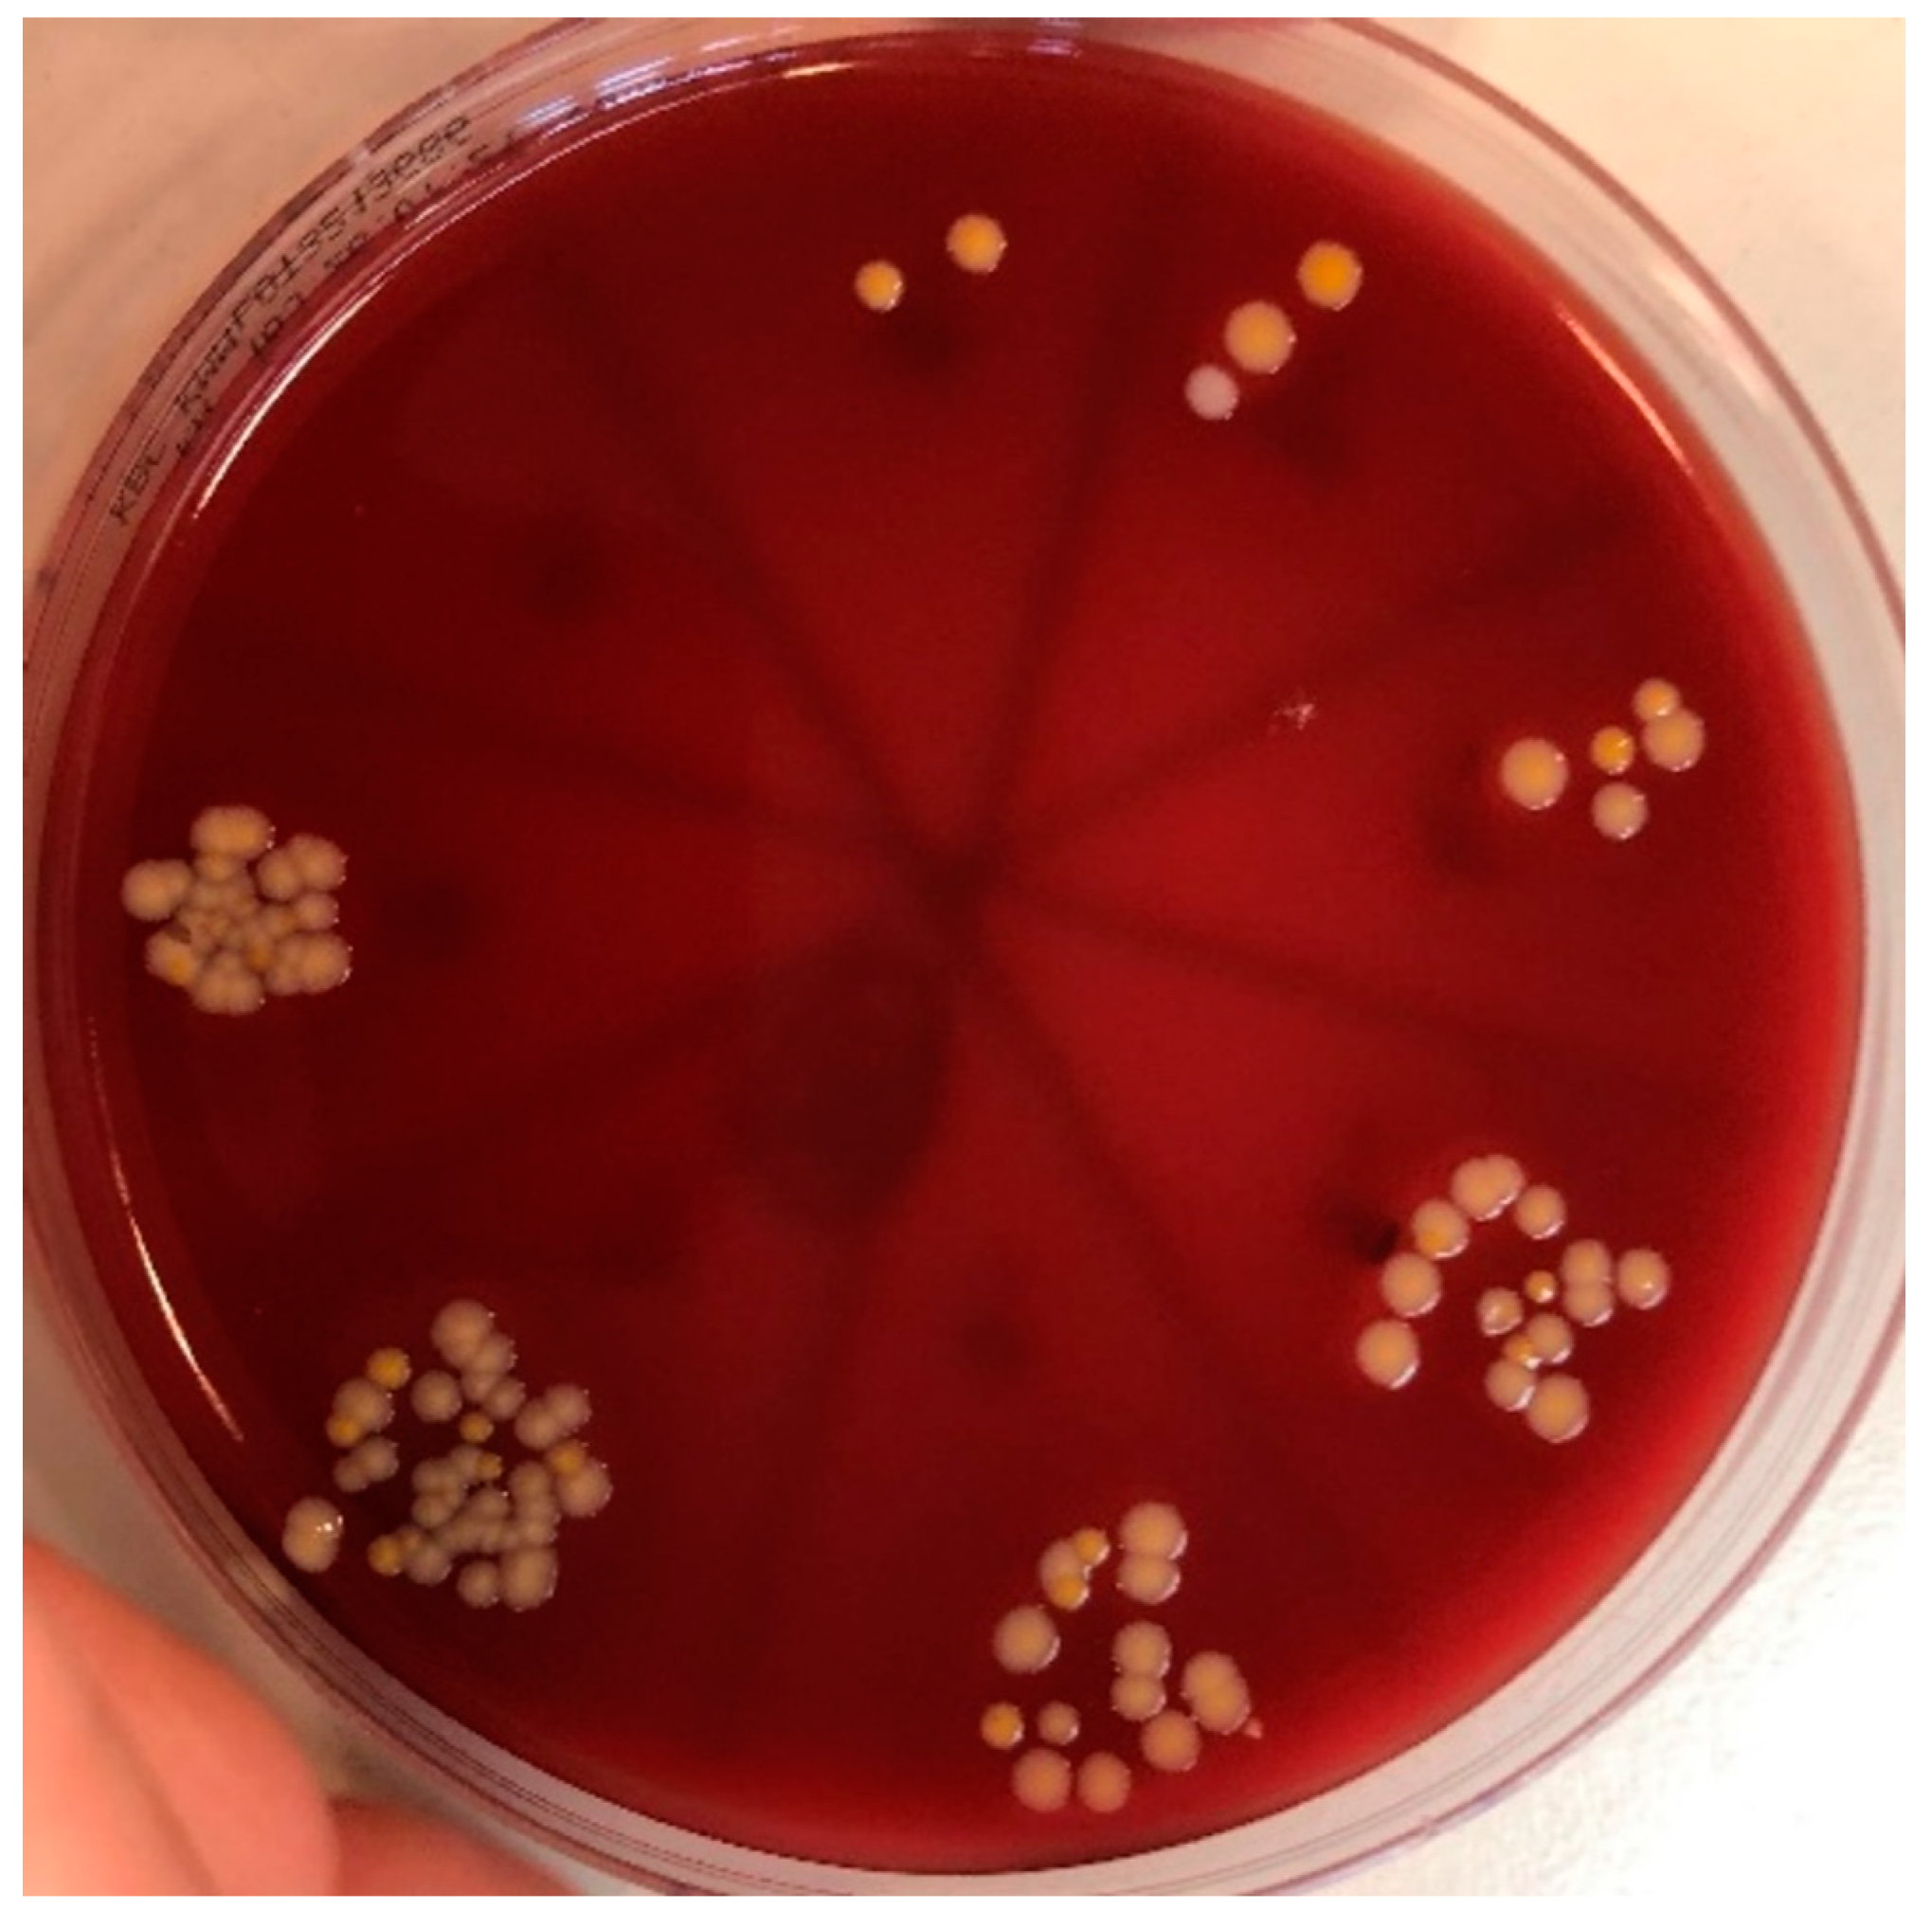
Biomedicines 11 01002 g005 Biomedicines 11 01002 g005

Evaluation of the Photoactivation Effect of 3% Hydrogen Peroxide in the Disinfection of Dental Implants: In Vitro Study
Abstract
1. Introduction
- Hydrogen peroxide activated by a 445 nm diode laser shows better results in disinfection of dental implants compared to hydrogen peroxide used without 445 nm photoactivation.
- Hydrogen peroxide activated by a 445 nm diode laser shows equal or better results in disinfection of dental implants compared to chlorhexidine treatment.
2. Materials and Methods
2.1. Disinfection Protocols
2.2. Collection of Samples

2.3. Statistical Analysis
3. Results
4. Discussion
5. Conclusions
Author Contributions
Funding
Institutional Review Board Statement
Informed Consent Statement
Data Availability Statement
Conflicts of Interest
References
- Tarnow, D.P. Commentary: Replacing Missing Teeth With Dental Implants: A Century of Progress. J. Periodontol. 2014, 85, 1475–1477. [Google Scholar] [CrossRef] [PubMed]
- Buser, D.; Sennerby, L.; De Bruyn, H. Modern implant dentistry based on osseointegration: 50 years of progress, current trends and open questions. Periodontology 2000 2017, 73, 7–21. [Google Scholar] [CrossRef]
- Albrektsson, T.; Donos, N. Implant survival and complications. The Third EAO consensus conference 2012. Clin. Oral Implant. Res. 2012, 23, 63–65. [Google Scholar] [CrossRef]
- Srinivasan, M.; Vazquez, L.; Rieder, P.; Moraguez, O.; Bernard, J.-P.; Belser, U.C. Survival rates of short (6 mm) micro-rough surface implants: A review of literature and meta-analysis. Clin. Oral Implant. Res. 2014, 25, 539–545. [Google Scholar] [CrossRef]
- Smeets, R.; Henningsen, A.; Jung, O.; Heiland, M.; Hammächer, C.; Stein, J.M. Definition, etiology, prevention and treatment of pe-ri-implantitis—A review. Head Face Med. 2014, 10, 34. [Google Scholar] [CrossRef]
- Atieh, M.A.; Alsabeeha, N.H.; Faggion, C.M., Jr.; Duncan, W.J. The frequency of peri-implant diseases: A systematic review and me-ta-analysis. J Periodontol. 2013, 84, 1586–1598. [Google Scholar] [CrossRef]
- Rams, T.E.; Degener, J.E.; Van Winkelhoff, A.J. Antibiotic resistance in human peri-implantitis microbiota. Clin. Oral Implant. Res. 2014, 25, 82–90. [Google Scholar] [CrossRef]
- Salvi, G.E.; Fürst, M.M.; Lang, N.P.; Persson, G.R. One-year bacterial colonization patterns of Staphylococcus aureus and other bacteria at implants and adjacent teeth. Clin. Oral Implant. Res. 2008, 19, 242–248. [Google Scholar] [CrossRef]
- Negrini, T.C.; Koo, H.; Arthur, R.A. Candida-Bacterial Biofilms and Host-Microbe Interactions in Oral Diseases. Adv. Exp. Med. Biol. 2019, 1197, 119–141. [Google Scholar]
- Otto, M. Staphylococcal biofilms. In Gram-Positive Pathogens, 3rd ed.; Fischetti, V.A., Novick, R.P., Eds.; John Wiley & Sons, Ltd.: Hoboken, NJ, USA, 2019; pp. 699–711. [Google Scholar]
- Harriott, M.M.; Noverr, M.C. Importance of Candida–bacterial polymicrobial biofilms in disease. Trends Microbiol. 2011, 19, 557–563. [Google Scholar] [CrossRef]
- De-La-Torre, J.; Quindós, G.; Marcos-Arias, C.; Marichalar-Mendia, X.; Gainza, M.L.; Eraso, E.; Acha-Sagredo, A.; Aguirre-Urizar, J.M. Oral Candida colonization in patients with chronic periodontitis. Is there any relationship? Rev. Iberoam. Micol. 2018, 35, 134–139. [Google Scholar] [CrossRef]
- Rokaya, D.; Srimaneepong, V.; Wisitrasameewon, W.; Humagain, M.; Thunyakitpisal, P. Peri-implantitis Update: Risk Indicators, Diagnosis, and Treatment. Eur. J. Dent. 2020, 14, 672–682. [Google Scholar] [CrossRef]
- Scarano, A.; Nardi, G.; Murmura, G.; Rapani, M.; Mortellaro, C. Evaluation of the Removal Bacteria on Failed Titanium Implants After Irradiation With Erbium-Doped Yttrium Aluminium Garnet Laser. J. Craniofacial Surg. 2016, 27, 1202–1204. [Google Scholar] [CrossRef]
- Memè, L.; Sartini, D.; Pozzi, V.; Emanuelli, M.; Strappa, E.M.; Bittarello, P.; Bambini, F.; Gallusi, G. Epithelial Biological Response to Machined Titanium vs. PVD Zirconium-Coated Titanium: An In Vitro Study. Materials 2022, 15, 7250. [Google Scholar] [CrossRef]
- Alovisi, M.; Carossa, M.; Mandras, N.; Roana, J.; Costalonga, M.; Cavallo, L.; Pira, E.; Putzu, M.G.; Bosio, D.; Roato, I.; et al. Disinfection and Biocompatibility of Titanium Surfaces Treated with Glycine Powder Airflow and Triple Antibiotic Mixture: An In Vitro Study. Materials 2022, 15, 4850. [Google Scholar] [CrossRef]
- Al-Hashedi, A.A.; Laurenti, M.; Benhamou, V.; Tamimi, F. Decontamination of titanium implants using physical methods. Clin. Oral Implant. Res. 2017, 28, 1013–1021. [Google Scholar] [CrossRef]
- Louropoulou, A.; Slot, D.E.; Van Der Weijden, F.A. Titanium surface alterations following the use of different mechanical instruments: A systematic review. Clin. Oral Implant. Res. 2012, 23, 643–658. [Google Scholar] [CrossRef]
- De Araújo Nobre, M.; Capelas, C.; Alves, A.; Almeida, T.; Carvalho, R.; Antunes, E.; Oliveira, D.; Cardador, A.; Maló, P. Non-surgical treatment of peri-implant pathology. Int. J. Dent. Hyg. 2006, 4, 84–90. [Google Scholar] [CrossRef]
- Marshall, M.V.; Cancro, L.P.; Fischman, S.L. Hydrogen Peroxide: A Review of Its Use in Dentistry. J. Periodontol. 1995, 66, 786–796. [Google Scholar] [CrossRef]
- Mahdi, Z.; Habiboallh, G.; Mahbobeh, N.N.; Mina, Z.J.; Majid, Z.; Nooshin, A. Lethal effect of blue light-activated hydrogen peroxide, curcumin and erythrosine as potential oral photosensitizers on the viability of Porphyromonas gingivalis and Fusobacterium nucleatum. Laser Ther. 2015, 24, 103–111. [Google Scholar] [CrossRef]
- Ehrenfest, D.M.D.; Del Corso, M.; Kang, B.S.; Leclercq, P. Identification card and codification of the chemical and morphological characteristics of 62 dental implant surfaces. Part 3: Sand-blasted/acid-etched (SLA type) and related surfaces (Group 2A, main subtractive process). Poseido 2014, 2, 37–55. [Google Scholar]
- Heitz-Mayfield, L.J.; Mombelli, A. The Therapy of Peri-implantitis: A Systematic Review. Int. J. Oral Maxillofac. Implant. 2014, 29, 325–345. [Google Scholar] [CrossRef] [PubMed]
- Chapple, I.L.C.; Matthews, J.B. The role of reactive oxygen and antioxidant species in periodontal tissue destruction. Periodontology 2000 2007, 43, 160–232. [Google Scholar] [CrossRef] [PubMed]
- Jaimes, E.A.; Sweeney, C.; Raij, L. Effects of the Reactive Oxygen Species Hydrogen Peroxide and Hypochlorite on Endothelial Nitric Oxide Production. Hypertension 2001, 38, 877–883. [Google Scholar] [CrossRef]
- Wiedmer, D.; Petersen, F.C.; Lönn-Stensrud, J.; Tiainen, H. Antibacterial effect of hydrogen peroxide-titanium dioxide suspensions in the decontamination of rough titanium surfaces. Biofouling 2017, 33, 451–459. [Google Scholar] [CrossRef]
- Teughels, W.; Van Assche, N.; Sliepen, I.; Quirynen, M. Effect of material characteristics and/or surface topography on biofilm development. Clin. Oral Implants Res. 2006, 17, 68–81. [Google Scholar] [CrossRef] [PubMed]
- Gustumhaugen, E.; Lönn-Stensrud, J.; Scheie, A.A.; Lyngstadaas, S.P.; Ekfeldt, A.; Taxt-Lamolle, S. Effect of chemical and mechanical debridement techniques on bacterial re-growth on rough titanium surfaces: An in vitro study. Clin. Oral Implants Res. 2014, 25, 707–713. [Google Scholar] [CrossRef]
- Charalampakis, G.; Belibasakis, G.N. Microbiome of peri-implant infections: Lessons from conventional, molecular and metagenomic analyses. Virulence 2015, 6, 183–187. [Google Scholar] [CrossRef] [PubMed]
- Marotti, J.; Tortamano, P.; Cai, S.; Ribeiro, M.S.; Franco, J.E.M.; De Campos, T.T. Decontamination of dental implant surfaces by means of photodynamic therapy. Lasers Med. Sci. 2013, 28, 303–309. [Google Scholar] [CrossRef]
- Olivi, G.; De Moor, R.; DiVito, E. Lasers in Endodontics: Scientific Background and Clinical Application, 1st ed.; Springer International Publishing: Cham, Switzerland; Heidelberg, Germany; New York, NY, USA; Dordrecht, The Netherlands; London, UK, 2016. [Google Scholar]
- Deppe, H.; Ahrens, M.; Behr, A.V.; Marr, C.; Sculean, A.; Mela, P.; Ritschl, L.M. Thermal effect of a 445 nm diode laser on five dental implant systems: An in vitro study. Sci. Rep. 2021, 11, 20174. [Google Scholar] [CrossRef] [PubMed]
- Malmqvist, S.; Liljeborg, A.; Qadri, T.; Johannsen, G.; Johannsen, A. Using 445 nm and 970 nm Lasers on Dental Implants—An In Vitro Study on Change in Temperature and Surface Alterations. Materials 2019, 12, 3934. [Google Scholar] [CrossRef] [PubMed]
- Valente, N.A.; Calascibetta, A.; Patianna, G.; Mang, T.; Hatton, M.; Andreana, S. Thermodynamic Effects of 3 Different Diode Lasers on an Implant-Bone Interface: An Ex-Vivo Study With Review of the Literature. J. Oral Implantol. 2017, 43, 94–99. [Google Scholar] [CrossRef] [PubMed]
- Matys, J.; Flieger, R.; Dominiak, M. Effect of diode lasers with wavelength of 445 and 980 nm on a temperature rise when un-covering implants for second stage surgery: An ex-vivo study in pigs. Adv. Clin. Exp. Med. 2017, 26, 687–693. [Google Scholar] [CrossRef]
- Geminiani, A.; Caton, J.G.; Romanos, G.E. Temperature change during non-contact diode laser irradiation of implant surfaces. Lasers Med. Sci. 2012, 27, 339–342. [Google Scholar] [CrossRef]
- Romanos, G.E. Diode laser soft-tissue surgery: Advancements aimed at consistent cutting, improved clinical outcomes. Compend. Contin. Educ. Dent. 2013, 34, 752–758. [Google Scholar] [PubMed]
- Cieplik, F.; Deng, D.; Crielaard, W.; Buchalla, W.; Hellwig, E.; Al-Ahmad, A.; Maisch, T. Antimicrobial photodynamic therapy. What we know and what we dont. Crit. Rev. Microbiol. 2018, 44, 571–589. [Google Scholar] [CrossRef] [PubMed]
- Kwiatkowski, S.; Knap, B.; Przystupski, D.; Saczko, J.; Kędzierska, E.; Knap-Czop, K.; Kotlińska, J.; Michel, O.; Kotowski, K.; Kulbacka, J. Photodynamic therapy—Mechanisms, photosensitizers and combinations. Biomed Pharmacother. 2018, 106, 1098–1107. [Google Scholar] [CrossRef]
- Katalinić, I.; Budimir, A.; Bošnjak, Z.; Jakovljević, S.; Anić, I. The photo-activated and photo-thermal effect of the 445/970 nm diode laser on the mixed biofilm inside root canals of human teeth in vitro: A pilot study. Photodiagnosis Photodyn. Ther. 2019, 26, 277–283. [Google Scholar] [CrossRef]
- Morelato, L.; Budimir, A.; Smojver, I.; Katalinić, I.; Vuletić, M.; Ajanović, M.; Gabrić, D. A Novel Technique for Disinfection Treatment of Contaminated Dental Implant Surface Using 0.1% Riboflavin and 445 nm Diode Laser-An In Vitro Study. Bioengineering 2022, 9, 308. [Google Scholar] [CrossRef]
- Ikai, H.; Nakamura, K.; Shirato, M.; Kanno, T.; Iwasawa, A.; Sasaki, K.; Niwano, Y.; Kohno, M. Photolysis of Hydrogen Peroxide, an Effective Disinfection System via Hydroxyl Radical Formation. Antimicrob. Agents Chemother. 2010, 54, 5086–5091. [Google Scholar] [CrossRef]
- Odor, A.A.; Bechir, E.S.; Forna, D.A. Effect of Hydrogen Peroxide Photoactivated Decontamination Using 940 nm Diode Laser in Periodontal Treatment: A Pilot Study. Photobiomodulation Photomed. Laser Surg. 2020, 38, 614–624. [Google Scholar] [CrossRef] [PubMed]
- Odor, A.A.; Bechir, E.S.; Violant, D.; Badea, V. Antimicrobial Effect of 940 nm Diode Laser based on Photolysis of Hydrogen Peroxide in the Treatment of Periodontal Disease. Rev. Chim. 2018, 69, 2081–2088. [Google Scholar] [CrossRef]

| CFU/mL S. aureus | Sample Size | Medium Value | Minimal Value | Maximal Value | Standard Deviation |
|---|---|---|---|---|---|
| Negative control | 20 | 286,731,516 | 20.00 | 2,000,000,000 | 508,403,118 |
| Positive control | 20 | 4 | 0.00 | 20 | 8.21 |
| 3% H2O2 | 20 | 134 | 0.00 | 2000 | 449.75 |
| Laser + 3% H2O2 | 20 | 45 | 0.00 | 200 | 79.97 |
| Mann-Whitney U Test By Variable CFU/mL S. aureus Marked Tests Are Significant at p < 0.05 | ||
|---|---|---|
| Protocol | p-value | 2 × 1 sided exact p |
| G1 vs. G2 | 0.000000 | 0.000000 |
| G2 vs. G3 | 0.059363 | 0.120700 |
| G2 vs. G4 | 0.326615 | 0.461169 |
| G3 vs. G4 | 0.501578 | 0.564832 |
| CFU/mL C. albicans | Sample Size | Medium Value | Minimal Value | Maximal Value | Standard Deviation |
|---|---|---|---|---|---|
| Negative control | 20 | 406,240 | 0.00 | 4,000,000 | 959,808 |
| Positive control | 20 | 20 | 0.00 | 200 | 61.56 |
| 3% H2O2 | 20 | 24 | 0.00 | 200 | 60.73 |
| Laser + H2O2 | 20 | 5 | 0.00 | 40 | 11.00 |
| Multiple Comparisons p-Values (2-Tailed); CFU/mL C. albicans Independent (Grouping) Variable: Protocol Kruskal–Wallis Test: H (3, N = 80) = 36.32679 p = 0.0000 | ||||
|---|---|---|---|---|
| Protocol | Negative Control R:63.30 | Positive Control R:30.10 | 3% H2O2 R:36.00 | Laser + H2O2 R:32.60 |
| Negative control | 0.000037 | 0.001219 | 0.000177 | |
| Positive control | 0.000037 | 1.000000 | 1.000000 | |
| 3% H2O2 | 0.001219 | 1.000000 | 1.000000 | |
| Laser + H2O2 | 0.000177 | 1.000000 | 1.000000 | |
Disclaimer/Publisher’s Note: The statements, opinions and data contained in all publications are solely those of the individual author(s) and contributor(s) and not of MDPI and/or the editor(s). MDPI and/or the editor(s) disclaim responsibility for any injury to people or property resulting from any ideas, methods, instructions or products referred to in the content. |
© 2023 by the authors. Licensee MDPI, Basel, Switzerland. This article is an open access article distributed under the terms and conditions of the Creative Commons Attribution (CC BY) license (https://creativecommons.org/licenses/by/4.0/).
Share and Cite
Katalinić, I.; Smojver, I.; Morelato, L.; Vuletić, M.; Budimir, A.; Gabrić, D. Evaluation of the Photoactivation Effect of 3% Hydrogen Peroxide in the Disinfection of Dental Implants: In Vitro Study. Biomedicines 2023, 11, 1002. https://doi.org/10.3390/biomedicines11041002
Katalinić I, Smojver I, Morelato L, Vuletić M, Budimir A, Gabrić D. Evaluation of the Photoactivation Effect of 3% Hydrogen Peroxide in the Disinfection of Dental Implants: In Vitro Study. Biomedicines. 2023; 11(4):1002. https://doi.org/10.3390/biomedicines11041002
Chicago/Turabian StyleKatalinić, Ivan, Igor Smojver, Luka Morelato, Marko Vuletić, Ana Budimir, and Dragana Gabrić. 2023. "Evaluation of the Photoactivation Effect of 3% Hydrogen Peroxide in the Disinfection of Dental Implants: In Vitro Study" Biomedicines 11, no. 4: 1002. https://doi.org/10.3390/biomedicines11041002
APA StyleKatalinić, I., Smojver, I., Morelato, L., Vuletić, M., Budimir, A., & Gabrić, D. (2023). Evaluation of the Photoactivation Effect of 3% Hydrogen Peroxide in the Disinfection of Dental Implants: In Vitro Study. Biomedicines, 11(4), 1002. https://doi.org/10.3390/biomedicines11041002

